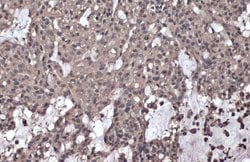
Invitrogen Phospho-IKK gamma (Ser376) Polyclonal Antibody 100 &mu;L; Unconjugated:Antibodies,

missing translation for 'onlineSavingsMsg'
Learn More
Learn More
Invitrogen™ Phospho-IKK gamma (Ser376) Polyclonal Antibody


Rabbit Polyclonal Antibody
Supplier: Invitrogen™ PA5117425
Description
Centrifuge briefly prior to opening.
IKK gamma is the regulatory subunit of the inhibitor of the kappaB kinase (IKK) complex, which activates NF-kappaB resulting in activation of genes involved in inflammation, immunity, cell survival, and other pathways. Mutations in this gene result in incontinentia pigmenti, hypohidrotic ectodermal dysplasia, and several other types of immunodeficiencies. Multiple transcript variants encoding different isoforms have been found for this gene. A pseudogene highly similar to this locus is located in an adjacent region of the X chromosome.Chemical Identifiers
| Phospho-IKK gamma (Ser376) | |
| Store at 4°C short term. For long term storage, store at -20°C, avoiding freeze/thaw cycles. | |
| Polyclonal | |
| Liquid | |
| IgG | |
| Human | |
| Ikbkg | |
| 1110037D23Rik; AI848108; AI851264; AMCBX1; AW124339; FIP3; FIP-3; Fip3p; gikk; I-kappa-B kinase gamma; I-kappa-B kinase subunit gamma; ikB kinase subunit gamma; ikB kinase-associated protein 1; IKBKG; IKK[g]; IKK3; IKKAP1; IKKG; IKK-gamma; IMD33; incontinentia pigmenti; inhibitor of kappa light polypeptide gene enhancer in B-cells, kinase gamma; inhibitor of kappaB kinase gamma; inhibitor of nuclear factor kappa-B kinase subunit gamma; IP; IP1; IP2; IPD2; mF; mFIP-3; Nemo; NF-kappa B essential modulator; NF-kappa-B essential modifier; NF-kappa-B essential modulator; OTTHUMP00000207079; OTTHUMP00000212188; ZC2HC9 | |
| Ikbkg | |
| Primary | |
| Antigen affinity chromatography |
| 1.68 mg/mL | |
| Immunohistochemistry (Paraffin), Western Blot | |
| Unconjugated | |
| Rabbit | |
| RUO | |
| PBS with 1% BSA, 20% glycerol and 0.025% ProClin 300; pH 7 | |
| Q9Y6K9 | |
| 8517 | |
| Carrier-protein conjugated synthetic peptide surrounding phospho Ser376 of human IKK gamma. The exact sequence is proprietary. | |
| Antibody |
Specifications
| Phospho-IKK gamma (Ser376) | |
| Polyclonal | |
| Unconjugated | |
| Ikbkg | |
| 1110037D23Rik; AI848108; AI851264; AMCBX1; AW124339; FIP3; FIP-3; Fip3p; gikk; I-kappa-B kinase gamma; I-kappa-B kinase subunit gamma; ikB kinase subunit gamma; ikB kinase-associated protein 1; IKBKG; IKK[g]; IKK3; IKKAP1; IKKG; IKK-gamma; IMD33; incontinentia pigmenti; inhibitor of kappa light polypeptide gene enhancer in B-cells, kinase gamma; inhibitor of kappaB kinase gamma; inhibitor of nuclear factor kappa-B kinase subunit gamma; IP; IP1; IP2; IPD2; mF; mFIP-3; Nemo; NF-kappa B essential modulator; NF-kappa-B essential modifier; NF-kappa-B essential modulator; OTTHUMP00000207079; OTTHUMP00000212188; ZC2HC9 | |
| Rabbit | |
| Antigen affinity chromatography | |
| RUO | |
| 8517 | |
| Store at 4°C short term. For long term storage, store at -20°C, avoiding freeze/thaw cycles. | |
| Liquid |
| Immunohistochemistry (Paraffin), Western Blot | |
| 1.68 mg/mL | |
| PBS with 1% BSA, 20% glycerol and 0.025% ProClin 300; pH 7 | |
| Q9Y6K9 | |
| Ikbkg | |
| Carrier-protein conjugated synthetic peptide surrounding phospho Ser376 of human IKK gamma. The exact sequence is proprietary. | |
| 100 μL | |
| Primary | |
| Human | |
| Antibody | |
| IgG |